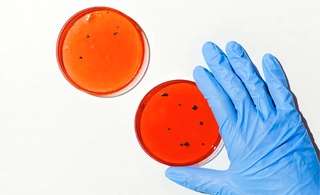
The Mystery of Oral Health: Scientific Analysis of Cell Renewal and Anti-Oral Aging

Oral health is a crucial aspect of our overall well-being. However, many individuals struggle with oral issues such as gum bleeding, oral inflammation, and periodontal diseases. One of the fundamental causes of these problems is the disruption of oral cell renewal and oral aging. This article delves into how to address these issues and restore oral health to its optimal state.
Cell Renewal and Maintenance:
Oral cell renewal is vital for maintaining the health of oral tissues. Disrupted cell renewal can lead to gum bleeding and oral inflammation. Proper oral hygiene, including regular brushing, flossing, and mouth rinsing, can help maintain normal cell renewal. Additionally, antioxidants and vitamins in our diet are crucial for cellular health.
Restoring Cell Vitality:
To combat oral aging, we need to find ways to restore the vitality of oral cells. While some cell regeneration therapies have shown promise in scientific research, they are still in the experimental stage. For daily care, opting for products containing growth factors or those suitable for oral health may help sustain cell vitality.
Gentle Deep Cleansing:
Gentle deep cleansing is crucial in preventing gum bleeding, oral inflammation, and periodontal diseases. Dental professionals can provide specialized oral cleaning to remove plaque and tartar. Additionally, mild oral care products can help maintain oral hygiene and reduce bacterial growth.
When addressing oral issues such as gum bleeding, oral inflammation, and periodontal diseases, nurturing oral cells from the root, restoring cell vitality, and ensuring gentle deep cleansing are pivotal factors. Sustained efforts in oral health maintenance are crucial for overall well-being. Through these scientific approaches, we can better understand and manage oral health, enhancing the radiance of our smiles.